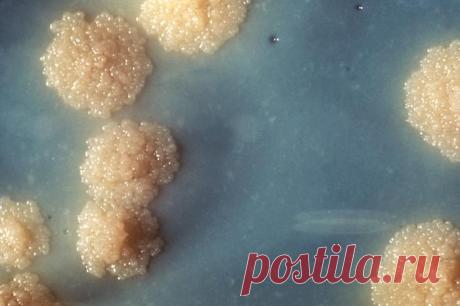
Mycobacterium tuberculosis - Wikipedia

cta.ru
Новый антибиотик открывает перспективу борьбы с супербактериями Медицинский мир ждал прорыва в антибиотиках почти тридцать лет. С каждым годом бактерии становятся все более устойчивыми к существующим препаратам, а устойчивость к антибиотикам (УПА) считается одной из самых серьезных угроз для глобального здравоохранения. Всемирная организация здравоохранения включает УПА в список десятки самых важных мировых проблем.
auto-ordnance.com
Auto Ordnance M1 Carbine - Auto-Ordnance | Original manufacturer of the world famous "Tommy Gun" OVERVIEW: AUTO-ORDNANCE M1 CARBINE OVERVIEW: AUTO-ORDNANCE M1 CARBINE The Auto-Ordnance M1 .30 Caliber carbine is produced in Kahr’s state-of-the-art manufacturing plant in Greeley, PA. All Auto-Ordnance carbines are produced using newly manufactured parts on high precision computerized machinery. Each Auto-Ordnance M1 Carbine is a faithful reproduction of the famous military r...